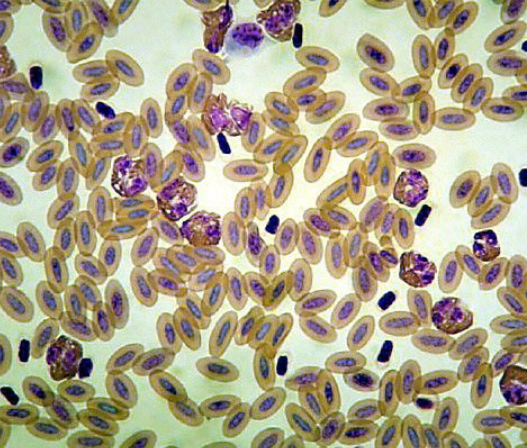

What radiographic views are best for the wings?
AV or skyline view
(Useful for intraosseous catheters)
Is this normal?

Yes!
What might tinted urine in bird feces indicate?
Liver problem

What’s wrong with this poop?
(#vetschoolproblems)

Contains digested blood (melena)
NOT to be confused with blood from stomach or intestines (below)

T/F: This is an example of an air sac that has popped out due to a puncture wound

FALSE
Air sacs do not pop out–air goes into the skin–> emphysema
How do you treat this?

Pop and give anti-inflammatories
What is the most common cause of this?
Which bacterial organism is mostly associated with these cases?

Cats
P. multocida
What happened?
What material is involved?
Would you treat surgically?

Shotgun pellets (from some dipshit)
Steel (smooth/round edges)
Would NOT treat surgically–too many/too deep; body just walls off foreign material
If a bird has a green wound is it bad/going to die??
Not necessarily
Bruising is green in birds–they lack the enzyme to breakdown bilirubin
Identify the major bones (Cruz’s faves) and the problem:

**luxation, not subluxation**

Is this a normal blood smear or is something wrong?

Abnormal–lead poisoning
What sample needs to be submitted to diagnose lead poisoning?
WHOLE BLOOD
Don’t be a narc and suggest only submitting plasma–you’ll be ridiculed in clinics
T/F: This is a normal blood smear
FALSE
Heterophilia–inflammatory process
Diagnosis?

Cataract
Diagnosis?
Treatment?

Sour crop
Remove, then administer pain meds, antibiotics, fluids, GI stimulants
What is the general fluid therapy guidelines for birds (maintenance, dehydration deficit)?
Maintenance = 50ml/kg/day
Formula for fluid therapy = %dehydration x BW(in grams)
Correct dehydration over a 3 day period
Is this a male or a female? Why?

Female
The long bones are bright = reproductive system = metabolically active tissue = female
What are the arrows pointing to?

Left = pectin
Right 2 = retinal tear/trauma
Diagnosis? What virus can cause it?

Mineralization
West Nile Virus
Species?
Problem?
Etiology?

Finch
Inflammation/problem with eyes (conjunctivitis)
Mycoplasma spp.
Etiology?

Mycobacterium tuberculosis (chronic)
T/F: This is the classic presentation of a liver infected with M**ycoplasma spp.

FALSE
Liver with Mycobacteriosis
Species?
Description of problems?
Diagnosis?

Red Tailed Hawk
Lesions around beak and on feet
Avian pox virus
What should you ALWAYS remember when handling birds?
DO NOT RESTRICT MOVEMENT OF THE KEEL AND RIBS
You will be a murderer. Shame on you.






























